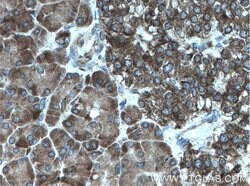
CDK5RAP3 Rabbit anti-Human, Polyclonal, Proteintech 20 &mu;L | Buy Online | Proteintech | Fisher Scientific

missing translation for 'onlineSavingsMsg'
Learn More
Learn More
Descripción
The protein encoded by this gene is one of the highly conserved mini-chromosome maintece proteins (MCM) that are involved in the initiation of eukaryotic genome replication. The hexameric protein complex formed by MCM proteins is a key component of the pre-replication complex (pre-RC) and it may be involved in the formation of replication forks and in the recruitment of other DNA replication related proteins. This protein can interact with MCM2 and MCM6, as well as with the origin recognition protein ORC2. It is regulated by proteolysis and phosphorylation in a cell cycle-dependent manner. Studies of a similar protein in Xenopus suggest that the chromatin binding of this protein at the onset of DNA replication is after pre-RC assembly and before origin unwinding. Alternatively spliced transcript variants encoding distinct isoforms have been identified.
Especificaciones
Especificaciones
| Antígeno | CDK5RAP3 |
| Aplicaciones | Immunocytochemistry, Immunohistochemistry (Paraffin), Immunofluorescence, Flow Cytometry, Western Blot |
| Clasificación | Polyclonal |
| Concentración | 0.13 mg/mL |
| Conjugado | Unconjugated |
| Formulación | PBS with 50% glycerol and 0.1% sodium azide; pH 7.3 |
| génica | CDK5RAP3 |
| N.º de referencia del gen | Q96JB5 |
| Alias de gen | C53, CDK5RAP3, HSF 27, IC53, LZAP, MST016, OK/SW cl.114, PP1553, Protein HSF 27 |
| Símbolos de los genes | CDK5RAP3 |
| Mostrar más |
Título del producto
Al hacer clic en Enviar, acepta que Fisher Scientific se ponga en contacto con usted en relación con los comentarios que ha proporcionado en este formulario. No compartiremos su información para ningún otro fin. Toda la información de contacto proporcionada se mantendrá de acuerdo con nuestra Política de Privacidad. Política de privacidad.
¿Detecta una oportunidad de mejora?